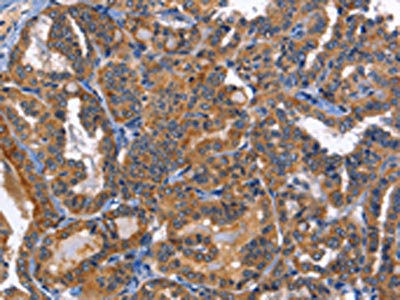

MUSK Antibody
-
中文名稱:MUSK兔多克隆抗體
-
貨號:CSB-PA989887
-
規格:¥1100
-
圖片:
-
The image on the left is immunohistochemistry of paraffin-embedded Human thyroid cancer tissue using CSB-PA989887(MUSK Antibody) at dilution 1/40, on the right is treated with fusion protein. (Original magnification: ×200)
-
The image on the left is immunohistochemistry of paraffin-embedded Human liver cancer tissue using CSB-PA989887(MUSK Antibody) at dilution 1/40, on the right is treated with fusion protein. (Original magnification: ×200)
-
-
其他:
產品詳情
-
Uniprot No.:
-
基因名:MUSK
-
別名:MUSK; Muscle, skeletal receptor tyrosine-protein kinase; Muscle-specific tyrosine-protein kinase receptor; MuSK; Muscle-specific kinase receptor
-
宿主:Rabbit
-
反應種屬:Human,Mouse,Rat
-
免疫原:Fusion protein of Human MUSK
-
免疫原種屬:Homo sapiens (Human)
-
標記方式:Non-conjugated
-
抗體亞型:IgG
-
純化方式:Antigen affinity purification
-
濃度:It differs from different batches. Please contact us to confirm it.
-
保存緩沖液:-20°C, pH7.4 PBS, 0.05% NaN3, 40% Glycerol
-
產品提供形式:Liquid
-
應用范圍:ELISA,IHC
-
推薦稀釋比:
Application Recommended Dilution ELISA 1:1000-1:5000 IHC 1:50-1:200 -
Protocols:
-
儲存條件:Upon receipt, store at -20°C or -80°C. Avoid repeated freeze.
-
貨期:Basically, we can dispatch the products out in 1-3 working days after receiving your orders. Delivery time maybe differs from different purchasing way or location, please kindly consult your local distributors for specific delivery time.
-
用途:For Research Use Only. Not for use in diagnostic or therapeutic procedures.
相關產品
靶點詳情
-
功能:Receptor tyrosine kinase which plays a central role in the formation and the maintenance of the neuromuscular junction (NMJ), the synapse between the motor neuron and the skeletal muscle. Recruitment of AGRIN by LRP4 to the MUSK signaling complex induces phosphorylation and activation of MUSK, the kinase of the complex. The activation of MUSK in myotubes regulates the formation of NMJs through the regulation of different processes including the specific expression of genes in subsynaptic nuclei, the reorganization of the actin cytoskeleton and the clustering of the acetylcholine receptors (AChR) in the postsynaptic membrane. May regulate AChR phosphorylation and clustering through activation of ABL1 and Src family kinases which in turn regulate MUSK. DVL1 and PAK1 that form a ternary complex with MUSK are also important for MUSK-dependent regulation of AChR clustering. May positively regulate Rho family GTPases through FNTA. Mediates the phosphorylation of FNTA which promotes prenylation, recruitment to membranes and activation of RAC1 a regulator of the actin cytoskeleton and of gene expression. Other effectors of the MUSK signaling include DNAJA3 which functions downstream of MUSK. May also play a role within the central nervous system by mediating cholinergic responses, synaptic plasticity and memory formation.
-
基因功能參考文獻:
- Gene expression profiling showed that MuSK was required for the BMP4-induced expression of a subset of genes in myoblasts, including regulator of G protein signaling 4 (Rgs4). PMID: 27601729
- Classical electromyography revealed the presence of myopathic changes more frequently in MuSK myasthenia gravis compared to acetylcholine receptor myasthenia gravis PMID: 26778359
- A Dutch founder mutation in MUSK causing fetal akinesia deformation sequence has been found in 14 fetuses. PMID: 25537362
- To our knowledge, this is the first report showing that a mutation in MuSK is associated with Fetal akinesia deformation sequence syndrome PMID: 25612909
- Immunosuppression attenuates the Th1 response in AChR-myasthenia gravis (MG) and MuSK-MG, but otherwise modulates immune responses in AChR-MG and MuSK-MG patients differentially. PMID: 25893403
- HnRNP C, YB-1 and hnRNP L coordinately enhance skipping of human MUSK exon 10 to generate a Wnt-insensitive MuSK isoform. PMID: 25354590
- MuSK myasthenia gravis IgG4 disrupts the interaction of LRP4 with MuSK but both IgG4 and IgG1-3 can disperse preformed agrin-independent AChR clusters PMID: 24244707
- [review] Recent discovery of two novel target proteins (MuSK and LRP4) has reduced the percentage of patients without known autoantibodies, although there are still some seronegative myasthenia gravis patients. PMID: 24530233
- Identification of a novel missense mutation c.114T > A; p.Asp38Glu heteroallelic to a genomic deletion encompassing exons 2-3 of MUSK that explain a limb-girdle congenital myasthenic syndrome in two affected brothers of a Turkish family. PMID: 24183479
- HEp-2 M4 cells revealed a high specificity for the detection of MuSK autoantibodies from 25 patient sera. PMID: 24416182
- This study provides a replication of the highly significant associations of both HLA-DRB1( *)16,-DRB1( *)14 and -DQB1( *)05 with MuSK-MG. PMID: 23993985
- pathogenic IgG4 antibodies to MuSK bind to a structural epitope in the first Ig-like domain of MuSK, prevent binding between MuSK and Lrp4, and inhibit Agrin-stimulated MuSK phosphorylation. PMID: 24297891
- We proved that the missense mutations in ColQ-CTD cause endplate AChE deficiency by compromising ColQ-MuSK interaction at the NMJ. PMID: 23553736
- MUSK is associated with a small but variable subgroup of distinct phenotypes in Thai patients with myasthenia gravis who have MUSK autoantibodies. PMID: 23352351
- MUSK antibodies may induce phenotypically disruptive actions at the neuromuscular junction by binding acetylcholinesterase (AChE) via its collagen tail, producing a reduction in synaptic AChE activity. PMID: 23720161
- MuSK is activated in a complex spatio-temporal manner to cluster acetylcholine receptors on the postsynaptic (muscle) side of the synapse and to induce differentiation of the nerve terminal on the presynaptic side. (Review) PMID: 23467009
- We report a novel mutation in MUSK leading to a Congenital myasthenic syndromes PMID: 23326516
- MuSK kinase activity is necessary for substrate-dependent acetylcholine receptor cluster formation PMID: 22210232
- Two family cases are reported that transmit MuSK antibody myasthenia gravis to the offspring by different maternal mechanisms. PMID: 21386774
- The ability of immobilized MuSK extracellular domain to remove practically all anti-MuSK antibodies from patients' sera should prove invaluable for development of an antigen-specific therapeutic approach for MuSK myasthenia gravis. PMID: 21993075
- Lrp4 is a cis-acting ligand for MuSK PMID: 21969364
- The importance of MuSK as a synapse organiser is highlighted by cases of autoimmune myasthenia gravis in which MuSK autoantibodies can deplete MuSK from the postsynaptic membrane, leading to complete disassembly of the adult neuromuscular junction. PMID: 20974278
- these findings demonstrate that missense mutations in MUSK can result in a severe form of congenital myasthenic syndrome and indicate that the inability of MuSK mutants to interact with Dok-7. PMID: 20371544
- Anti-MuSK protein positive patients have more predominantly bulbar involvement and had more severe myasthenia gravis. PMID: 19327804
- analysis of regulation of MuSK expression by a novel signaling pathway PMID: 12885777
- Missense mutation does not affect MuSK catalytic kinase activity but diminishes expression and stability. PMID: 15496425
- Thus, an agrin/MuSK complex may form part of a motor neuron stop signal involved in "reverse signaling" to the motor neuron. PMID: 15691710
- A low-molecular weight isoform of muscle-specific receptor tyrosine kinase in human sperm localized in the flagellar mid-piece region. PMID: 16487930
- Dok-7 is essential for neuromuscular synaptogenesis through its interaction with MuSK PMID: 16794080
- Altogether, these results indicate that anti-MuSK Abs could be pathogenic by contributing to the muscle atrophy in MuSK+ MG patients. PMID: 16857268
- muscle-specific receptor tyrosine kinase activation and binding to dystroglycan are regulated by alternative mRNA splicing of agrin PMID: 17012237
- Testing of human myotubes for the presence and activation of MuSK by exposing them to laminin. PMID: 17192614
- We describe a case of epileptic seizures secondary to myasthenia gravis caused by autoantibodies to the MUSK receptor. These autoantibodies affected the brain as well. PMID: 17661994
- the COOH-terminal NES and Src homology 2 target motifs play key roles in Dok-7/MuSK signaling for neuromuscular synaptogenesis. PMID: 18165682
- We describe a transient neonatal myasthenic syndrome with anti-musk antibodies. PMID: 18378885
- IgG from anti-MuSK-positive patients can cause myasthenia gravis when injected into mice. PMID: 18384168
- single-fiber electromyography of distal limb muscles tends to have a lower yield of abnormality in MuSK-antibody-positive patients than either acetylcholine receptor-antibody-positive or seronegative myasthenia gravis PMID: 18567855
- Thymectomy is mostly considered scarcely effective; however, at present, no firm conclusions can be drawn on its role in the treatment of this form of myasthenia gravis PMID: 18567856
- Anti-MuSK antibodies influence the activity of MuSK molecules without reducing their number, thereby diminishing the size of the endplate and affecting the functioning of acetylcholine receptors. PMID: 19745065
- This study report a family known so far with a congenital myasthenic syndromes due to a mutation in the MUSK gene. PMID: 19949040
顯示更多
收起更多
-
相關疾病:Myasthenic syndrome, congenital, 9, associated with acetylcholine receptor deficiency (CMS9); Fetal akinesia deformation sequence (FADS)
-
亞細胞定位:Cell junction, synapse, postsynaptic cell membrane; Single-pass type I membrane protein.
-
蛋白家族:Protein kinase superfamily, Tyr protein kinase family
-
數據庫鏈接:
Most popular with customers
-
-
Phospho-YAP1 (S127) Recombinant Monoclonal Antibody
Applications: ELISA, WB, IHC
Species Reactivity: Human
-
-
-
-
-
-